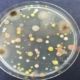

Privacy o sicurezza? La videosorveglianza nell’era degli algoritmi
La videosorveglianza nell’era degli algoritmi.
Andrea Carobene, Head of Data and Digital Management di United Risk management, ha pubblicato sul numero 4 della rivista Aggiornamenti Sociali un’analisi dei rapporti tra videosorveglianza e intelligenza artificiali, mostrando le implicazioni che questa tecnologia ha sulla nostra Società in vari campi, compreso quello della rigenerazione urbana e delle aree abbandonate. “Oggi non è possibile pensare la nostra Società senza le telecamere”.
© United Risk Management